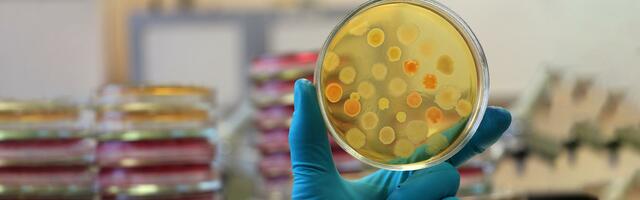
ultimos descubrimientos a la microbiologia

-
habla sobre dos reinos el
plantae: algas y hongos
animal: protozoos -
Anton Van Leevwenhoek observo los animcaulos con un microscopio de un solo lente que el contruyo
-
Eugenio espejo el fue el primero en referir la existencia del microrganismo causante de la viruela
-
Pierre fauchard introdujo los conceptos de biofilm y sarro dental en la aparacion de procesos periodontales
-
Biologo que confirma que los micriorganismos unicelulares eran seres vivios y es responsable de la insiminación artificial en animales
-
propueso la teoria de la generación espontanea el cual decia que podria salir vida de materia inorganica y organica por medio de experimentos, ademas creo un metodo de conservación llamado pastreurización y encontro la vacuna de la rabia y carbunco
-
Descubrio el Bacilotuberculosis y la colera y es el fundador de la bacteriologia
-
Joseph Lister descubrio que el proceso de fermentacion es debido a un microrganismo y es el creador del concepto antisepsia
-
conocido por haber descubierto el agente patógeno causante de la enfermedad de transmisión sexual: gonorrea
-
Alphonse laverin fue el primer cientifico frances en ganar el nobel por encontrar el protozoos causante de la malaria
-
se demstro que con azul de metileno se podrian ver mejor los microorganismos
-
alexander fleming descubrio este medicmanete a partir del hongo penicillium
-
crea la teoria de quimio parasitario o enfermedades gingivales
-
Dice que el acido que sueltan las bacterias son los causantes de las caries dental destruyente el tejido dental
-
-
se descubrieron unas enzimas presentes en determinadas bacterias que eran capaces de romper el ADN extraño que podía infectarlas.
-
es el fundador de la taxonomia molecular y el funador del dominio bacteria, dominio eucarya y archea
-
Logran almacenar datos digitales en el ADN de bacterias vivas a continuacion el link de la noticia .(https://www.investigacionyciencia.es/noticias/logran-almacenar-datos-digitales-en-el-adn-de-bacterias-vivas-19437)
-
Es una enfermedad infecciosa causada por el SARS-COV 2 que actualemnte por la gran cantidad de contaminados estamos en pandemia
Plan projects on a visual timeline
Map milestones, phases, deadlines, and key events in one place so the sequence is easier to see and share. Timetoast is a timeline maker for work, school, research, and stories.